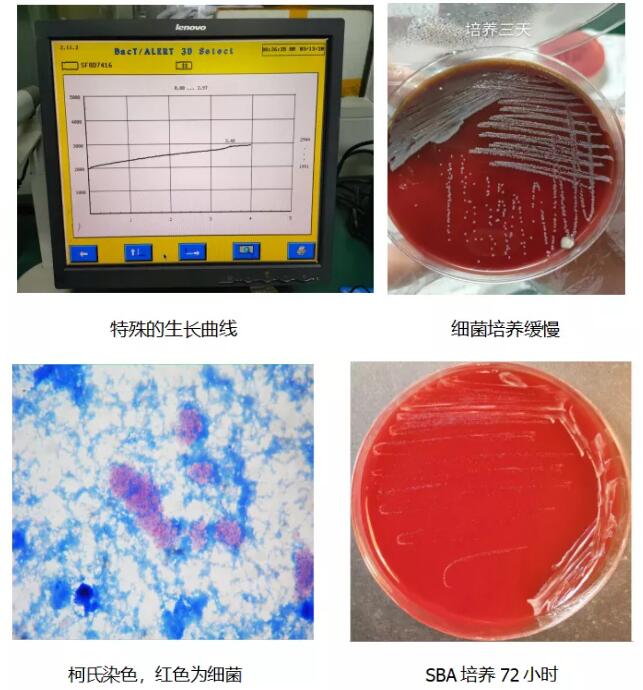

探菌之谜案――市二医院检测出首例布鲁菌感染病例
近日,市二医院一名患者血培养第四天报阳性,经涂片染色、分离培养及生化实验等最后鉴定为马耳他布鲁菌(羊布鲁菌),这是近年医院发现的第一例布鲁菌感染病例。
当前,我国正处于抗击新冠疫情的关键时期,据了解,该患者于1个月前出现无明显诱因的腰部疼痛,活动受限伴寒战、发热,在当地社区医院对症治疗后症状缓解。家人及患者本人近14天内无接触“新冠肺炎”疫区人员及去过流行病疫区,瓷都健康码显本色,后因双下肢乏力来医院行增强MRI检查提示椎管内感染而收治入院。患者血培养阳性,由于该菌生长曲线异于常见阳性瓶典型的S型生长曲线,基于细菌生长速度、染色特征、镜下形态及病人所住科室综合判断,初步怀疑布鲁氏菌。与经管医生沟通得知病人有绵羊及羊粪接触史,临床症状也与布鲁氏菌病相符。由于布鲁氏菌为高致病力细菌,易导致实验室人员感染,被认为是潜在的生物恐怖病原菌。在充分做好生物安全防护的情况下做了鉴定,鉴定结果为马耳他布鲁菌(羊布鲁菌)。
布鲁氏菌病(又称布鲁菌病,简称布病)是由布鲁氏菌感染引起的一种人畜共患疾病。患病的羊、牛等疫畜是布病的主要传染源,布鲁氏菌可以通过破损的皮肤黏膜、消化道和呼吸道等途径传播。急性期病例以发热、乏力、多汗、肌肉、关节疼痛和肝、脾、淋巴结肿大为主要表现。慢性期病例多表现为关节损害等。是我国《传染病防治法》规定的乙类传染病。

布鲁菌病为动物源性,其传播途径有:
①消化道。未煮熟的牛羊肉,或未经消毒或消毒不充分的牛、羊奶中含有足够多的病原体时,即可通过消化道传播。由于羊布鲁菌比其他种类布鲁菌对胃酸具有更强抗性而易于存活。
②破损皮肤粘膜。接触感染动物的皮毛时,可通过皮肤破损处而感染。
③气溶胶。通过呼吸道吸入而感染。此途径是动物皮毛加工者与实验室人员感染的主要原因。因此,在布鲁菌流行区域,微生物实验室工作人员应严格遵守生物安全防护规则。
由于人与人间传播罕见,病人无须特殊隔离。但哺乳妇女感染布鲁菌后可由乳汁传至婴儿,或器官移植供体传至受体。布鲁菌是胞内寄生菌,主要寄生在巨噬细胞内,因此易导致慢性感染,治疗也不太容易。因此对布鲁菌感染患者的抗感染治疗应注意选用能进入巨噬细胞的抗菌药物,并坚持连续应用以彻底消灭胞内细菌。

